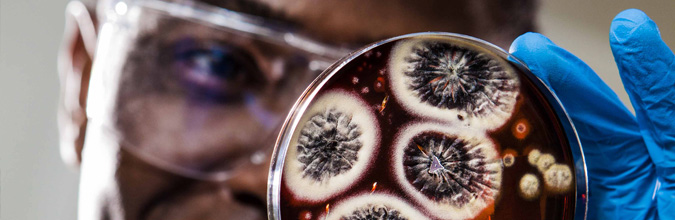
Image of article Bringing together local pathology services

A dedicated logistic network, gives us the speed to serve you quickly, and the redundancy to serve you reliably. Our highly experienced team provide you with a comprehensive service. Our network is our strength, and at every turn we use our size and reach to deliver cutting edge pathology services.
MoreA dedicated logistic network, gives us the speed to serve you quickly, and the redundancy to serve you reliably. Our highly experienced team provide you with a comprehensive service. Our network is our strength, and at every turn we use our size and reach to deliver cutting edge pathology services.
MoreTo view our tests, pick a department from the list on the left. Alternatively, you can search for a test from the search box above.
To view our products, pick a category from the list on the left. To order products, log in by clicking +Login on the top right side of the page.
Berkshire and Surrey Pathology Services (BSPS) team are employed by each of the partner Trusts depending on the location.
The new BSPS Lighthouse Laboratory is now testing COVID-19 swabs as part of the national testing effort to help tackle the coronavirus.
Pathology services previously delivered by the Surrey and Sussex Healthcare NHS Trust (SASH) have formally joined the NHS-run Berkshire and Surrey Pathology Services (BSPS) network. The integration is in line with national policy to develop larger pathology service providers. It increases the resilience of local pathology services and means that SASH pathology services are joining a single managed pathology service for the entire Surrey Heartlands ICS with end-to-end IT connectivity across the whole area.
Since signing the Managed Services Contract with Abbott in early 2022, we have been progressively upgrading our analytical equipment at all sites across the network and we are implementing automation at the hub sites of Frimley, Wexham and St Peters.